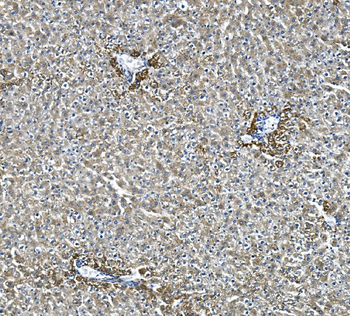
Glycine decarboxylase/GLDC Rabbit Polyclonal Antibody

You have no items in your shopping cart.
All Products
- Claudin 7/CLDN-7/CLDN Rabbit Polyclonal Antibody [orb738379]
ELISA, FC, ICC, IF, IHC, WB
Human
Rabbit
Polyclonal
Unconjugated
100 μg - NEFL/NF-L/NF Rabbit Polyclonal Antibody [orb738390]
ELISA, FC, IF, IHC, WB
Human, Mouse, Rat
Rabbit
Polyclonal
Unconjugated
100 μg - PARP/PARP1 Mouse Monoclonal Antibody [orb738402]
FC, ICC, IF, IHC, WB
Human, Mouse, Rat
Mouse
Monoclonal
Unconjugated
100 μg - MPI Mouse Monoclonal Antibody [orb738403]
FC, ICC, IF, IHC, WB
Human, Rat
Mouse
Monoclonal
Unconjugated
100 μg ELISA, FC, IHC, WB
Human, Mouse, Rat
Rabbit
Polyclonal
Unconjugated
100 μg- OTULIN Rabbit Polyclonal Antibody [orb670317]
ELISA, FC, ICC, IF, IHC, WB
Human, Mouse, Rat
Rabbit
Polyclonal
Unconjugated
100 μg - TBP-1/PSMC3/TBP Rabbit Polyclonal Antibody [orb670321]
ELISA, FC, IHC, WB
Human, Mouse, Rat
Rabbit
Polyclonal
Unconjugated
100 μg - GILT/IFI30 Rabbit Polyclonal Antibody [orb669182]
FC, IF, IHC, WB
Mouse, Rat
Rabbit
Polyclonal
Unconjugated
100 μg - RGS6 Rabbit Polyclonal Antibody [orb669243]
ELISA, FC, IHC, WB
Human, Mouse, Rat
Rabbit
Polyclonal
Unconjugated
100 μg - MCU Rabbit Polyclonal Antibody [orb669189]
ELISA, FC, IHC, WB
Human, Monkey, Mouse, Rat
Rabbit
Polyclonal
Unconjugated
100 μg